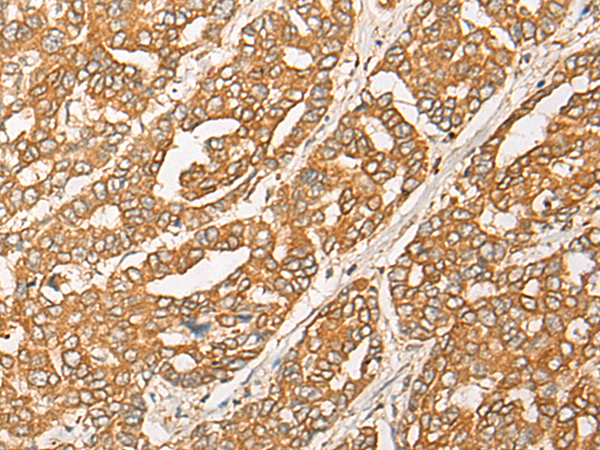

-
分类: 科研抗体货号: P06307别名: SUR2; CRSP3; MRT18; SUR-2; ARC130; CRSP130; CRSP133; DRIP130应用: IHC反应种属: Human, Mouse, Rat
-
分类: 科研抗体货号: P06321别名: GY2; FKSG1; WDR14; WDVCF; DGCRK3应用: IHC反应种属: Human, Mouse
-
分类: 科研抗体货号: P06328别名: PAP1应用: WB,IHC反应种属: Human, Mouse
-
分类: 科研抗体货号: P06304别名: AIT; SMCT; SMCT1应用: WB反应种属: Human
-
分类: 科研抗体货号: P06319别名: UV20; COFS4; RAD10应用: IHC反应种属: Human, Mouse
-
分类: 科研抗体货号: P06327别名: PL; HOX1; HOX1H; HOX1.8应用: WB,IHC反应种属: Human, Mouse
-
分类: 科研抗体货号: P06359别名: C2orf37应用: IHC反应种属: Human, Mouse, Rat
-
分类: 科研抗体货号: P06318别名: NC2; NC2B; NC2-BETA应用: IHC反应种属: Human, Mouse, Rat
-
分类: 科研抗体货号: P06325别名: EAG2; hEAG2; H-EAG2; Kv10.2应用: IHC反应种属: Human, Mouse, Rat
-
分类: 科研抗体货号: P06356别名:应用: IHC反应种属: Human, Mouse, Rat

鄂公网安备42018502007531号
鄂公网安备42018502007531号

